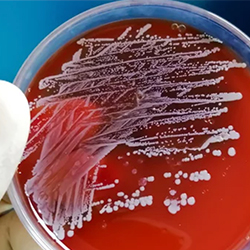

Early initiation of a combination of remdesivir (Veklury, Gilead Sciences) and corticosteroids (CCS) in patients with chronic obstructive pulmonary disease (COPD) hospitalized with SARS-CoV-2 infection significantly improved mortality in this high-risk patient population, compared with those who were initiated on CCS only, according to a new study.

“SARS-CoV-2 infection remains prevalent and continues to burden health systems worldwide, especially in vulnerable individuals who are immunocompromised, elderly or have comorbidities such as COPD,” said study author Susan Spivey-O’Neal, PharmD, the director of COVID-19 strategy at Gilead Sciences.
She noted that not only do patients with COPD have a higher risk for SARS-CoV-2 infection, but once infected, they also face worse outcomes than those without COPD (BMJ Open Respir Res 2025;12[1]:e002694).
In the study, presented at MAD-ID 2025 (abstract 39 OR), in Orlando, Fla., the international team of investigators conducted a comparative effectiveness study using real-world data from the PINC AI healthcare database from December 2021 to February 2024. They compared clinical outcomes in patients with COPD hospitalized for SARS-CoV-2 infection who either initiated remdesivir with corticosteroids upon admission or were treated with CCS alone, stratified by baseline supplemental oxygen requirements. The analysis population included 39,383 patients with COPD, 24,084 (61%) of whom initiated both remdesivir and CCS, and 15,299 (39%) of whom initiated CCS only during the baseline period.
Benefit in Adding Remdesivir
They found that remdesivir provided a significant survival benefit in patients hospitalized with SARS-CoV-2 infection regardless of disease severity or oxygen support requirements at admission.
Those initiated on remdesivir and CCS upon admission had a statistically significant 20% to 28% decrease in mortality risk across all supplemental oxygen requirements, compared with those initiated on CCS only. Lower mortality risk was found at 14 and 28 days with an overall adjusted hazard ratio (aHR) of 0.74 (95% CI, 0.68-0.80) and 0.76 (95% CI, 0.71-0.82).
Initiation of remdesivir was also associated with a lower mortality risk at 14 days for patients not receiving supplemental oxygen (aHR, 0.75; 95% CI, 0.64-0.89); those receiving low-flow oxygen (aHR, 0.71; 95% CI, 0.62-0.81); those receiving high-flow oxygen or noninvasive mechanical ventilation (aHR, 0.72; 95% CI, 0.63-0.83); and those receiving invasive mechanical ventilation/extracorporeal membrane oxygenation (aHR, 0.70; 95% CI, 0.55-0.90).
“These results highlight the benefit of timely remdesivir treatment in COPD patients hospitalized with SARS-CoV-2 infection and underscore the value of considering established treatment paradigms in the context of the most recent collective evidence,” Dr. Spivey-O’Neal said. “There is a continuing need to evolve and optimize SARS-CoV-2 infection treatment in patients with COPD and other vulnerable patients at risk of severe SARS-CoV-2 infection by considering the totality of evidence, including the most recent evidence.”
The study was sponsored by Gilead Sciences, and multiple study co-authors reported employment by and/or holding stock in and/or consulting fees from Gilead Sciences.